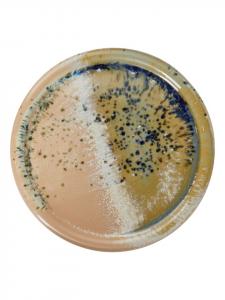
Тарелка для завтрака SINTRA синего цвета Butlers

Тарелки
12241 товар
12241 товар